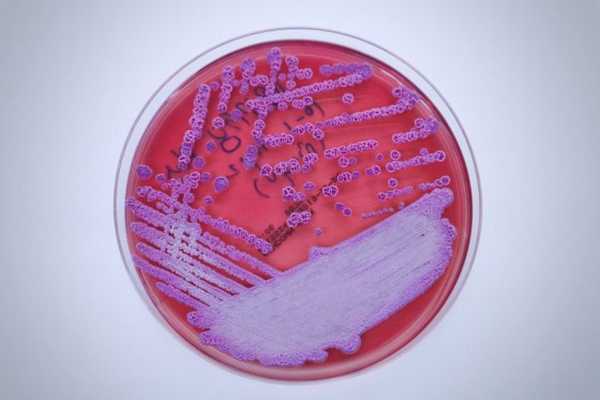

Механизм развития мелиоидоза. Клиника мелиоидоза
Добавил пользователь Валентин П. Обновлено: 28.01.2026
Медицинская микробиология:
Эпидемиология мелиоидоза
Первоначально (в первой половине XX в.) роль источника инфекции отводилась диким грызунам, больным хронической формой мелиоидоза, так как было показано, что больные животные выделяют возбудитель во внешнюю среду на всем протяжении заболевания. Однако в дальнейшем при анализе вспышек мелиоидоза на эндемичных территориях было твердо установлено, что при этом заболевании нет случаев передачи инфекции от больного животного здоровому.
Более того, при переводе стада с одного места содержания на другое после ликвидации явно больных животных эпизоотия возникала только в тех местах, где из внешней среды выделяли культуру В. pseudomallei. Постепенно главенствующим среди эпидемиологов стало положение, согласно которому основным резервуаром инфекции на эндемичных по мелиоидозу территориях считается почва и вода.
В. pseudomallei является естественным обитателем почвы и выявляется с одинаковой частотой как в сельскохозяйственных регионах, городах, так и в девственных лесах. Тщательный анализ эпизоотий на этих территориях показал, что при данной инфекции в принципе нет классического эпизоотического процесса, а заражение животных разной степени интенсивности носит характер не связанных между собой отдельных заболеваний.
Характер протекания такого рода вспышек в основном зависит от времени года и сопутствующей концентрации возбудителя в поверхностных слоях почвы. Поэтому в настоящее время общепризнанным является отнесение мелиоидоза к сапронозам.
Заражение человека происходит при заглатывании большою количества возбудителя с водой, например при купании в стоячих водоемах, при работе на рисовых полях. Возбудитель проникает в организм человека через поврежденную кожу и слизистые оболочки и ингаляционно — в составе пылевого аэрозоля.
Наиболее вероятными путями завоза на неэндемичные территории следуют считать пополнение зоопарков экзотическими животными, а также импорт скота из стран Юго-Восточной Азии, Западной Африки, Ирана и Австралии. Поэтому целесообразно периодически проводить анализ заболеваемости животных в карантинных пунктах и зоопарках.
Учитывая высокий процент лиц, серопозитивных по мелиоидозу, лицам, проживающим или находившимся в длительных командировках на эндемичных территориях, в ряде стран делается специальная пометка в медицинской карте, что позволяет практикующему врачу заподозрить возможность обострения хронической или инаппарантной формы мелиоидоза при возникновении лихорадочного состояния, артритов и абсцессов неясной этиологии.
Мелиоидоз
Мелиоидоз (ложный сап, болезнь Уитмора) - острая инфекционная болезнь, протекающая в виде тяжелого сепсиса с образованием множественных абсцессов в различных органах или в виде относительно доброкачественных легочных форм.
Что провоцирует / Причины Мелиоидоза:
Возбудитель мелоидоза - Pseudomonas pseiidomallei (бацилла Уитмора). Представляет собой грамотрицательную, биполярно окрашивающуюся палочку длиной 2-6 мкм и шириной 0,5-1 мкм. Аэроб имеет жгутики, подвижен, хорошо растет на питательных средах. Возбудитель длительно сохраняется во внешней среде. Во влажной среде выживает до 30 дней, в гниющих материалах - 24 дня, в воде - до месяца и более. Погибает при нагревании и под воздействием дезинфицирующих средств. Различают 2 антигенных типа возбудителя: тип I (азиатский), широко распространенный повсюду, включая Австралию, и тип II (австралийский), распространенный преимущественно в Австралии. Патогенность этих типов существенно не различается. Возбудитель чувствителен к левомицетину, тетрациклину, канамицину, некоторым сульфаниламидным препаратам.
В эндемичных по мелиоидозу регионах основным резервуаром возбудителя в природе являются почва и вода, загрязненные выделениями инфицированных животных. В этих районах возбудитель может быть выделен из почвы, стоячих водоемов, прудов, рисовых плантаций. Животные выделяют возбудителя с мочой и испражнениями, сами инфицируются при употреблении кормов и воды. Мелиоидозная инфекция может наблюдаться у многих видов животных: крыс, мышевидных грызунов, кроликов, коров, собак, кошек, кенгуру и др. Членистоногие не участвуют в передаче инфекции. В эндемичных районах мелиоидоз распространен широко, о чем свидетельствует тот факт, что у 7-10% взрослого населения этих районов обнаруживают антитела к возбудителю мелиоидоза. Заражение человека может наступать при употреблении инфицированной пищи или воды, а также аэрогенным путем (воздушно-пылевым). Часто инфицирование наступает при загрязнении мелких повреждений кожи почвой. Заражение человека от человека наблюдается крайне редко. Описан случай половой передачи инфекции больным хроническим простатитом (в секрете предстательной железы выявлен возбудитель мелиоидоза) супруге, которая никогда не была в эндемичных районах. Выявлено заболевание медицинской сестры, которая не была в эндемичных районах, но работала в палатах для больных мелиоидозом. Это указывает на возможность внутрибольничной инфекции лиц с ослабленным иммунитетом.
Патогенез (что происходит?) во время Мелиоидоза:
Воротами инфекции являются мелкие повреждения кожи или слизистой оболочки органов пищеварения или респираторного тракта. Лимфогенно возбудитель достигает регионарных лимфатических узлов, где размножается иногда с образованием гнойного очага. При септических формах мелиоидоза возбудитель проникает в кровь и гематогенно распространяется по различным органам и системам, образуя там множество вторичных очагов с казеозным распадом и абсцессами. Большинство очагов развивается в легких, единичные абсцессы - в других органах. При подостром течении очаги в легких характеризуются большими размерами, а вторичные очаги обнаруживаются во всех органах и тканях - коже, подкожной клетчатке, печени, селезенке, почках, в костях, в мозговых оболочках, головном мозге, в лимфатических узлах. Вторичные очаги состоят из центральной зоны казеозного некроза, окруженной грануляционной тканью. Кальцификаты не развиваются. Септическое течение мелиоидоза наблюдается у резко ослабленных лиц. При хорошей реактивности макроорганизма чаще возникают относительно доброкачественно протекающие легочные абсцессы, при которых воспалительные изменения и абсцессы развиваются лишь в легких. Вероятно, мелиоидоз может протекать и в виде латентной инфекции. Например, в США наблюдались случаи мелиоидоза у лиц, которые несколько лет назад возвратились из эндемичных районов Юго-Восточной Азии. После перенесенного мелиоидоза в крови появляются антитела. Случаи повторного заболевания мелиоидозом не описаны.
Симптомы Мелиоидоза:
Инкубационный период мелоидоза продолжается всего 2-3 дня (по данным лабораторных заражений со времени повреждения кожи и до развития болезни). Основные клинические формы:
1) септическая (острая, подострая, хроническая);
2) легочная (инфильтративная, абсцедирующая);
3) рецидивирующая;
4) латентная.
Очень быстрое развитие септической инфекции наблюдается у ослабленных лиц (наркоманы, диабетики, больные алкоголизмом и др.). В этих случаях быстро нарастают лихорадка и признаки общей интоксикации. Одновременно появляются признаки поражения легких и множественные поражения других органов. Отмечается фарингит, пустулезная сыпь по всему телу, жидкий водянистый стул, выраженная одышка, цианоз. У части больных появляются гнойные артриты, менингит, нарушение сознания. При рентгенографии легких отмечаются узелковые затенения диаметром около 10 мм, склонные к слиянию в более крупные инфильтраты. Эти формы болезни обычно не поддаются терапии.
При подострых и хронических формах мелоидоза отмечается более длительное течение с образованием вяло текущих абсцессов в различных органах и тканях. Эти формы периодически дают ремиссии, однако без этиотропной терапии больные также умирают в течение месяца (подострые формы) или через несколько месяцев (хронические формы).
Легочная форма мелоидоза может начинаться внезапно, но чаще это заболевание развивается исподволь, иной раз выявляется даже случайно при рентгенологических исследованиях. Основные признаки этой формы мелиоидоза - повышение температуры тела, кашель с гнойной, иногда кровянистой мокротой, нарастающая слабость, исхудание, боли в груди. Лихорадка имеет обычно неправильный или интермиттирующий характер с ознобом и потом. У больных появляются кашель с большим количеством гнойной мокроты, колющие боли в грудной клетке, понижается аппетит, отмечается слабость; потеря массы тела составляет в среднем 10-15 кг. Гемограмма: нейтрофильный лейкоцитоз, повышенная СОЭ. При рентгенологическом исследовании изменения очень сходны с туберкулезными. Поражаются чаще верхние доли, у большинства больных с образованием тонкостенных полостей диаметром 1-4 см. У некоторых больных может быть несколько полостей (2-3 и более). Иногда поражение легких протекает в виде инфильтратов без казеозного распада и образования полостей.
Рецидивирующий мелиоидоз. Возбудитель мелиоидоза может длительно сохраняться в организме в виде латентной инфекции. Активизация латентной инфекции может проявляться в виде острого септического или легочного заболевания или в виде хронического локализованного гнойного заболевания. Рецидив развивается через длительное время после первичного инфицирования. Описан случай рецидива через 26 лет после заражения. Рецидив может быть спровоцирован хирургическим вмешательством, тяжелой гриппозной пневмонией, лучевой терапией и пр. Необходимо учитывать активизацию латентной мелиоидозной инфекции у больных СПИДом.
Диагностика Мелиоидоза:
Диагноз ставится комплексно, учитываются эпизоотические данные, клинические признаки, патологоанатомические изменения и результаты бактериологических исследований. Для выделения чистой культуры делают высевы из патматериала на МПА, МПБ, МПЖ. Биопробу ставят, вводя материал морским свинкам под кожу (самцам можно в брюшную полость), животные погибают на 10-20-й день (у самцов развивается орхит и перитонит, при подкожном введении - язва на месте инъекции).
Клинический диагноз септических форм мелиоидоза не представляет больших трудностей. Имеет значение пребывание в эндемичной местности, тяжелое течение болезни, прогрессирующая дыхательная недостаточность, множественные пустулезные элементы на коже, множественные абсцессы в подкожной клетчатке, мышцах и внутренних органах.
Пневмонические формы мелиоидоза можно диагностировать на основании эпидемиологических предпосылок, подострого течения пневмонии с поражением верхних долей, с ранним образованием тонкостенных полостей, кашля с гнойной или кровянистой мокротой, похудания, неправильной лихорадки с периодически возникающими ознобами.
Из лабораторных методов используют выделение возбудителей (из крови, гноя абсцессов, мокроты). Используют серологические реакции. РСК со специфическим антигеном считается диагностической уже в титре 1:8 и выше. Отрицательная РСК не исключает возможности мелиоидоза. Более чувствительна реакция гемагглютинации, которая рано становится положительной в титрах 1:16-1:64.
Дифференцируют от сапа, туберкулеза легких, глубоких микозов.
Лечение Мелиоидоза:
Используется длительная этиотроппая терапия. Наиболее эффективными являются тетрациклины, левомицетин и бактрим (бисептол). Тетрациклин назначают в дозе 3 г в сутки (40 мг/кг), левомицетин по 0,75 г через 6 ч (40 мг/кг сут) в течение не менее 30 дней. Co-trimoxazoie (триметоприм - сульфаметоксазол) назначают в дозе 4 мг/кг триме-таприма и 20 мг/кг сульфаметоксазола в сутки в течение 60-150 дней. При тяжелых септических формах в настоящее время рекомендуют назначать 4-6 г тетрациклина в сутки (80 мг/кг), 4~6 г левомицетина (80 мг/кг сут) и одного из следующих препаратов: триметоприм - сульфаметоксазол (9 мг/кг триметоприма и 45 мг/кг сульфаметоксазола), канамицин (30 мг/кг) или новобиоцин (60 мг/кг). Антибиотики следует вводить парентерально [Sandford J. Р., 1989, 1993].
Прогноз. До введения в практику антибиотиков смертность при септических формах приближалась к 100%, при современных методах лечения при септических формах умирает около 50% и более. При других формах мелиоидоза прогноз более благоприятный. Вероятность отдаленных рецидивов около 20%.
Профилактика Мелиоидоза:
Специфическая профилактика не разработана. Больные мелиоидозом подлежат изоляции и госпитализации. В эндемичной местности проводят мероприятия по уничтожению грызунов и защите от них продуктов. Запрещается употребление сырой воды и купание в стоячих водоемах.
При подозрении на мелиоидоз больных животных изолируют и исследуют бактериологически. В неблагополучном хозяйстве проводят дезинфекцию, дератизацию и дезинсекцию. Убой на мясо больных и подозрительных по заболеванию животных запрещают.
К каким докторам следует обращаться если у Вас Мелиоидоз :
Вас что-то беспокоит? Вы хотите узнать более детальную информацию о Мелиоидоза, ее причинах, симптомах, методах лечения и профилактики, ходе течения болезни и соблюдении диеты после нее? Или же Вам необходим осмотр? Вы можете записаться на прием к доктору .
Механизм развития мелиоидоза. Клиника мелиоидоза
Миаз, myiasis (от греч. myia - муха, иные транскрипции: myiosis, myasis) - заболевание, вызываемое проникновением и пребыванием личинок и взрослых особей членистоногих в тканях и полостях организма человека.
Обычно эти насекомые (мухи) питаются начавшими разлагаться веществами животного и растительного происхождения; миаз поэтому обычно возникает исключительно в местах с плохими санитарно-гигиеническими условиями; в большинстве случаев заражение происходит в результате случайной небрежности человека. У человека болезнь могут вызывать различные виды этих насекомых.
Эндемичные районы - тропические районы Африки, Южной Америки, Мексика, Калифорния и Новая Гвинея.
Что провоцирует / Причины Миаза:
Основные возбудители миаза - личинки мухи тумбу (Cordylobia anthropophaga) и песчаная блоха (Tunga penetrans), самки которой проникают в кожу по сделанным ими ходам, где оплодотворённое животное раздувается от яиц до размеров горошины, вызывая развитие болезненных изъязвлений.
В отечественной практике известны случаи паразитирования у человека личинок вольфартовой мухи (Wohlfahrtia magnifica) и различных оводов (обычно русского и овечьего).
Представители рода Gastcrophilus, Hypoderma, Dermatobia и Cordylobia поражают кожу; Fannia поражают пищеварительный тракт и мочевую систему; Phonnia и Wohlfahrtia могут заражать открытые раны и язвы; Oestrus поражают глаза; а также Cochliomyia проникают в носовые ходы и осуществляют их инвазию.
Личинки мух сравнительно стойки по отношению к различным факторам, в частности к химическим реагентам. Можно отметить способность «крыски» - личинки мухи Eristalis к обитанию в сточных водах и др. весьма загрязненных местах (скопление жидких фекалий и др.); личинки многих мух долго по сравнению с личинками других насекомых не гибнут в растворах формалина или спирта. Все эти особенности личинок мух определяют их способность жить тот или другой срок в необычной для них среде, например, в кишечнике человека, куда они могут попасть с пищей.
Патогенез (что происходит?) во время Миаза:
Взрослые особи мух откладывают яйца в глаза, уши, нос, раны людей либо вводят их подкожно. Реже наблюдают висцеральные поражения, обусловленные случайным заглатыванием личинок.
Миаз классифицируют как по месту нахождения личинок в хозяине, так и по биологичеким свойствам личинок соответствующих видов мух.
Миазы делятся на случайные, факультативные и облигатные.
- Случайные миазы вызывают личинки тех видов мух, которые в норме развиваются в гниющих веществах. В организм человека они попадают случайно. Мухи откладывают яйца на продукты питания, бельё, и т.п. Вышедшие из яиц личинки могут быть проглочены вместе с пищей. С белья личинки могут заползти в уретру. Таким образом человек заражается кишечным или уринарным миазом.
- Облигатные миазы ведут исключительно паразитический образ жизни, поражая различных травоядных.
- Факультативные миазы вызывают случайные поражения (например, поражения, вызванные мясными или комнатными мухами).
По локализации различают миаз кожный, тканевой, полостной (ухо, нос), кишечный, миаз мочевых путей, половых органов и глазной.
- Кожный (тканевой) миаз в свою очередь бывает разных форм.
- Эпидермальный миаз; личинки живут в толще эпидермиса и не выходят за его пределы (например, личинка 1-й фазы овода Gastrophilus, вызывающая creeping disease).
- Подкожный миаз с локализацией личинок в соединительнотканных слоях кожи, причем вторично может поражаться и эпидермис (например, кожный овод коров Hypoderma, личинки которого могут гостепаразитировать и у человека); соответствующая форма миаза получила название подкожного миаза с передвигающимся опуханием кожи над мигрирующей личинкой; личинки кожного человеческого овода Dermatobia и мухи Cordylobia. anthropophaga вызывают развитие фурункулезного миаза.
- Подкожный миаз может переходить в тканевой, когда личинки мух попадают в язвы или раны и начинают разъедать живую ткань тела хозяина; в конечном счете могут происходить огромные разрушения мягких частей тела. Такие формы миаза иногда принимают генерализованный характер и могут быть причиной смерти хозяина (например, известные из истории случаи «заедания червями» (т. е. личинками мух) человека насмерть); тканевой миаз, в частности миаз ран, вызывается как облигатными (личинки Вольфартовой мухи), так и факультативными паразитами (личинки падальной мухи (Lucilia), комнатной мухой (Musca domestica), мясной мухой (Calliphora), ochliomyia macellaria, Pycnosoma и др.)
- В овечьем оводе (Oestrus ovis), или же вбуравливаются в мягкие покровы и разрушают их (Вольфартова муха).
- Полости рта - в деснах, разрушая их мягкие части (например, Вольфартова муха); это явление по-видимому настолько нередкое, что в народе зубную боль этиологически связывали с нахождением во рту «червей».
- Слуховом проходе (otomyiasis) - Вольфартова муха и др.; Миаз здесь обычно развивается на почве каких-либо заболеваний уха; личинки могут разрушать барабанную перепонку, среднее ухо, проникать в сосцевидный отросток, венозный синус и доходить до мозговых оболочек (последствия - вплоть до смертельного исхода).
- Мочевых путях и пузыре - личинки Anthomyia (Fannia) canicularis, Musca domestica.
- Пoловыx органах - личинки Вольфартовой мухи (в половой щели овец).
Во всех этих случаях заражение хозяина происходит пассивно. Одни мухи отрождают в его полости, в глаз, в язвы или раны свои личинки, другие откладывают туда же яйца, из которых вылупляются личинки уже в организме хозяина. Личинки некоторых видов (Cordylobia) активно вбуравливаются в кожу человека. Бывают примеры нахождения даже окуклившихся стадиев в хозяине, поэтому понятие миаза распространяется на все случаи нахождения каких-либо стадиев метаморфоза мух от яйца до puparium в хозяине или на нем.
- Кишечным миазом называют случаи пребывания живых личинок мух в желудке или в кишечнике человека.
Заражение пищеварительного тракта личинками происходит вследствие заглатывания их с пищей или с каким-либо другим материалом. Личинки сырной мухи (Piophila casei) живут в соленой рыбе, сыре и могут быть легко съедены; другие мухи могут откладывать яйца в уже приготовленную пищу (например, вареное мясо), причем на этом же субстрате развиваются и личинки. Нередки случаи получения личинок с овощами и т. д.
Симптомы кишечного миаза различны. При локализации личинок в желудке бывают тошнота, рвота и резкая боль в области эпигастрия. При нахождении их в кишечнике на первый план выступают боли живота, геморагии и тифоидное состояние. При длительном нахождении личинок мух в кишечнике развивается колит. В пищеварительном тракте человека могут жить различные виды мух: комнатная муха, мясная муха, падальная муха, сырная муха (Piophila casei), Anthomyia (Fannia) canicularis, Anthomyia scalaris, Eristalis, Philaematomyia и др.
Диагноз кишечного миаза необходимо ставить с осторожностью, чтобы отличить подлинные случаи миаза от мнимых. К последним относят случаи, когда пациенты умышленно вводят врача в заблуждение, принося «паразитов», якобы вышедших из кишечника. Мухи могут отложить яйца в уже выделенные испражнения, и из яиц могут успеть вылупиться личинки, прежде чем кал попадет к врачу для исследования; в последнем случае все личинки будут очень малых размеров (около 1 мм), тогда как взрослые личинки достигают 1-1,5 см длины, а иногда и более.
Симптомы Миаза:
Поражения при миазе обычно протекают остро. Личинки могут выедать все мягкие ткани до костей. Снаружи ход личинки представляет красноватое нитевидное утолщение кожных покровов.
Клинически поражения внутренних органов напоминают симптомы перфорации кишечника или абсцессов паренхиматозных органов.
Выделяют следующие виды миаза:
- Гастрофилёз (gastrophilosis) - разновидность Larva migrans, возбудителем которой является личинка овода (Gastrophilus equi), паразитирующая в желудке и кишечнике лошадей. Личинки желудочного овода мигрируют в эпидермисе кожи, проделывая за сутки ход длиной от 7-8 до 30 см.
- Дерматобиаз (dermatobiasis) - тропический миаз, вызываемый личинкой овода (Dermatobia hominis), характеризующийся образованием в коже абсцедирующего узла вокруг внедрившегося возбудителя.
- Кордилобиоз (m. africana; син. Миаз африканский) - тропический миаз, вызываемый личинкой мухи Cordylobia anthropophaga и характеризующийся образованием в коже абсцедирующего узла вокруг внедрившегося возбудителя.
Лечение Миаза:
Лечение кожного миаза заключается в удалении личинок оводов из проделываемых ими ходов, извлечении этих личинок из ран и язв, прикладывании тампонов с хлороформом, антисептическом лечении язв и ран; из глаза личинок оводов удаляют пинцетом или промыванием, из желудка - промыванием, из кишечника - различными противоглистными средствами.
Профилактика Миаза:
Лечение язв на теле домашних животных для уничтожения в них личинок мух, лечение язв и ран, чтобы гнойным отделением они не привлекали к себе мух» защита пищевых продуктов от мух, потребление в пищу хорошо вымытых и очищенных овощей, особенно если последние используются в свежем виде; сжигание трупов и падали.
К каким докторам следует обращаться если у Вас Миаз:
Вас что-то беспокоит? Вы хотите узнать более детальную информацию о Миаза, ее причинах, симптомах, методах лечения и профилактики, ходе течения болезни и соблюдении диеты после нее? Или же Вам необходим осмотр? Вы можете записаться на прием к доктору .
Клиника и патогенез мелиоидоза
Патогенез мелиоидоза изучен недостаточно. Было показано, что в фильтратах бульонных культур имеется по меньшей мере два термолабильных фактора с токсическим эффектом. Один из них — дермонекротический токсин по своей природе относится к протеазам и вызывает при внутрикожном введении уже через несколько часов глубокий некроз кожи и прилежащих тканей.
Второй — так называемый летальный токсин является необычным белком массой 31 кД, сохраняющим свою растворимость и стабильность в 80% спирте. Активность обоих термолабильных токсинов не коррелирует ни с морфологией колоний, ни с вирулентностью штаммов. Не имеется и зависимости между резистентностью животных к мелиоидозу и чувствительностью их к этим токсинам. По всей видимости, патогенез мелиоидоза не детерминирован каким-то одним фактором. Термолабильный летальный токсин, вероятно, является или второстепенным, или же равным по своему значению многочисленным факторам патогенности (мукоид, лецитиназа, эндотоксин и пр.).
Кроме того, в фильтратах культур обнаруживаются рамнолипид и пептидный антиген малой молекулярной массы (3 кД), обладающие выраженным цитотоксическим эффектом.
Патоморфологические данные мелиоидозной инфекции широко варьируют в зависимости от локализации очагов поражения и длительности течения заболевания. При этом отмечается высокая степень сходства патологоанатомической картины у человека и теплокровных животных.
Для септицемической формы характерно полнокровие и наличие точечных кровоизлияний в коже и слизистых, увеличение регионарных лимфатических узлов. В легких, печени и селезенке обнаруживаются многочисленные узелки, содержащие монокультуру возбудителя в высокой концентрации. Чем длительнее протекает процесс, тем более выражены изменения во внутренних органах; происходит слияние гнойников в крупные абсцессы.
При подострых формах многочисленные абсцессы выявляются в легких, лимфатических узлах и паренхиматозных органах. При генерализации инфекции поражения в виде гнойников и флегмон выявляют на коже, в подкожной клетчатке, мышцах и костях.
Практически при любой клинической форме отмечается поражение легких. Считается, что легочная ткань обладает повышенной чувствительностью к возбудителю мелиоидоза. Так, по данным таиландских специалистов, при септицемических формах легкие поражаются у 90% пациентов, а в суммарном обобщении на 1000 леченных в клинике больных у 66% выявляется легочная патология. Причем чаще поражаются верхняя и нижняя доли правого легкого. Размер абсцессов может варьировать в широких пределах; располагаются они как в глубине легочной ткани, так и под плеврой, при этом возможно сращение легкого с плеврой.
Определенное место в клинических поражениях занимают локальные формы, среди которых выделяют поражения мочеполовой системы (абсцессы почек, циститы, эпидидимиты), встречаются остеомиелиты, гнойные абсцессы мышц, простаты, у детей нередко развиваются паротиты и отиты.
Клиническая картина мелиоидоза у человека и животных довольно разнообразна, и на данный момент сформулировать типичные проявления заболевания представляется затруднительным. Клинический диагноз мелиоидоза без серологических и бактериологических данных поставить исключительно сложно. В зависимости от превалирующей симптоматики поражения органов и скорости течения выделяют следующие формы заболевания:
1. Молниеносная (септическая) форма. Характеризуется бурным лихорадочным началом, ознобом, нарушением сознания. Длительность течения — 2-5 дней. на фоне тяжелой и высокой (до 41"С и выше) лихорадки появляется многократная рвота и частый жидкий стул энтеритного характера, что приводит к эксикозу. Прогноз всегда неблагоприятный. По течению эта форма мелиоидоза весьма напоминает холеру и септическую форму чумы. Специфическая культура выделяется из крови, мокроты и мочи. Серологическим методом подтвердить диагноз не удается.
Ничего общего по своей клинической форме, кроме скорости течения, не имеет с молниеносной формой так называемый синдром внезапной смерти. При его формировании практически отсутствуют продромальные симптомы, за несколько часов до смерти могут быть жалобы на головную боль, а сама смерть наступает ночью при признаках удушья. На вскрытии отмечаются лишь некоторые отклонения от нормы при исследовании почек, во внутренних органах нет характерных для мелиоидоза поражения. В сыворотке от этих больных при постановке РНГА отмечаются диагностические титры специфических антител.
Полагают, что смертельный исход при этом синдроме обусловлен анафилактической реакцией или воздействием летального экзотоксина.
2. Острая септицемическая форма. По своей симптоматике напоминает брюшной тиф. Отмечаются симптомы расстройства функции желудочно-кишечного тракта, общая слабость, лихорадка, мучительные головные боли. На кожных покровах и слизистых появляются пустулы, геморрагии, изъязвления. Выделения из этих участков поражения содержат в достаточно высоких концентрациях возбудитель, идентификация которого и позволяет установить окончательный диагноз. Серологичекие реакции положительны в 50-90% случаев. На вскрытии у больных септицемической формой отмечаются множественные некротические и геморрагические поражения легких, лимфатических узлов, внутренних органов. Продолжительность острой формы мелиоидоза — 7-15 дней. Исход в нелеченных случаях всегда смертельный.
3. Подострая форма. Заболевание протекает относительно медленно. Симптоматика целиком зависит от локализации и множественности специфических абсцессов. Иногда эту форму дополнительно разграничивают на легочную и экстрапульмональную. Легочная форма напоминает по своей симптоматике туберкулез (одно из первых названий мелиоидоза — «вьетнамский туберкулез»), но без характерной для последнего избирательности поражений верхних долей легкого. Культура у этих больных, как правило, выделяется из мокроты, реже из крови.
Практически в 100% случаев диагноз подтверждается в РНГА с антигенным эритроцитарным диагностикумом. В отличие от предыдущих двух форм летальность при современных методах лечения подострой формы гораздо ниже (10-20%), но следует помнить, что после кажущегося выздоровления в 15-30% случаев возможны рецидивы, наступающие через 3-12 мес. после выписки пациента из больницы.
4. Хроническая форма. Основной клинический признак — локальные длительно не заживающие абсцессы. Локализация — лимфоузлы, подкожная клетчатка, мышцы, кости и суставы. Септицемия отсутствует. Заболевание длится годами, у больных отмечается кратковременное повышение температуры, слабость, истощение. Нередко диагноз ставится как случайная находка, гораздо чаще — при обострении на основании анамнеза и данных бактериологического анализа. Исход заболевания зависит от ряда составляющих — локализации специфических очагов, причин, вызвавших обострение.
5. Инаппарантная форма. Случаи заболевания людей мелиоидозом через многие годы после возвращения из эндемичных районов поставили на повестку дня вопрос о необходимости длительного и систематического медицинского наблюдения за этими лицами, тем более, если у них отмечаются высокие титры специфических антител при серологическом исследовании сывороток в РНГА.
Мелиоидоз: аромат бактериологической войны
![]()
Летом 2021 года эксперты из CDC (U.S. Centers for Disease Control and Prevention) сообщили о нескольких случаях редкого, но очень опасного заболевания под названием «мелиоидоз», причиной которого стал ароматерапевтический спрей Better Homes & Gardens из Индии. Всего было выявлено 4 случая мелиоидоза, 2 из которых закончились смертью пациентов.
Крупная розничная сеть Walmart немедленно отозвала все ароматерапевтические спреи данной марки и призвала тех, кто успел купить их, не открывать, не выкидывать флаконы, а аккуратно запаковать в пакетик и вернуть в любой магазин сети с получением компенсации. Если же продукт успели начать использовать, следовало все отмыть, промыть, простирать и просушить, тщательно при этом моя руки. А уж если у покупателя поднялась температура, то следовало немедленно, сию секунду вызывать врача.
Возникает вопрос: почему все так переполошились? Что это за болезнь - мелиоидоз, разбирался MedAboutMe.
Мелиоидоз и его возбудитель
![Мелиоидоз и его возбудитель]()
Мелиоидоз - это бактериальная инфекция, поражающая животных и людей. Впервые о ней сообщил в 1912 году майор британской медслужбы А.Уитмор. В Бирме он обследовал трупы морфинистов, которые скончались от сепсиса, и обнаружил у них язвы и абсцессы, схожие с теми, что образуются при сапе.
Сап - это зоонозное инфекционное заболевание, которое, как следует из определения, может передаваться от животных к человеку. Болеют им лошади, верблюды и ослы. Могут также болеть представители кошачьих и медведи. Возбудителем является бактерия Burkholderia mallei.
К счастью, это заболевание встречается очень редко. Но его летальность стала причиной того, что сап в ряде стран планировалось использовать в качестве биологического оружия. Было это во времена, когда армии мира активно использовали лошадей на войне. Однако лошади из армии практически ушли, а люди все-таки существенно менее восприимчивы к этой инфекции. Так что идея использовать Burkholderia mallei как бактериологическое оружие пока отпала. Этому также способствуют ряд международных конвенций.
Когда майор Уитмор выделил из язв возбудителя болезни, он обнаружил, что эта грамоотрицательная палочковидная бактерия очень напоминает возбудителя сапа. Он назвал свою находку Bacillus pseudomallei. А чуть позже эту же бактерию другие ученые нашли у грызунов и больных домашних животных в том же регионе. Новая болезнь получила название «мелиоидоз».
Сегодня и бактерия, вызывающая сап, и возбудитель мелиоидоза относятся к одному роду буркхолдерий - Burkholderia. Из 80 его членов только 4 являются патогенами человека.
Где можно заразиться буркхолдериями?
Как отмечается в статье, опубликованной в 2014 году в журнале «Проблемы особо опасных инфекций», буркхолдерии - весьма крепкие создания. Они устойчивы к перепадам температур, к кислоте и щелочам, дезинфицирующим средствам и антисептикам. Они умеют выживать в клетках иммунной системы, распространяться по межклеточному пространству и образовывать биопленки - структуры, особенно стойкие к внешним воздействиям.
Удивительно, но мелиоидозом люди заражаются вовсе не от животных, хотя им болеют более 50 видов млекопитающих и птиц. Разбор случаев заражения показывает, что люди подхватывают инфекцию из внешней среды. В субтропиках заболеваемость мелиоидозом четко коррелирует с климатическими колебаниями: в сезон дождей растет число случаев заболевания и среди людей, и среди животных. Поэтому врачи и ученые считают мелиоидоз не зоо-, а сапронозной инфекцией, то есть для ее возбудителя основное место обитания - неживые объекты окружающей среды: почвы и поверхностные воды, а также клетки растений.
К счастью, в России в живой, так сказать, природе буркхолдерий не встретишь. Эта бактерия - эндемик северной Австралии, Индии и некоторых районов Юго-Восточной Азии.
Регионы, в которых буркхолдерии чувствуют себя хорошо, расположены между 20° северной и 20° южной широты. Идеальная для них температура воздуха составляет 24-32 °С, а влажность - более 40%. Что не может не радовать — в наших широтах буркхолдериям не выжить.
Сегодня смертность госпитализированных с мелиоидозом пациентов в Таиланде составляет 30-35%, в Австралии - меньше, 14%. В среднем по всему миру смертность от этого заболевания составляет от 20 до 50%.
Ежегодно во всем мире регистрируется примерно 165 тысяч случаев мелиоидоза, из которых 89 тысяч заканчиваются смертью зараженного человека.
«Великий имитатор»
![«Великий имитатор»]()
Симптомы мелиоидоза могут напоминать многие другие заболевания - сепсис, пневмонию, туберкулез и др. Поэтому среди врачей мелиоидоз известен как «великий имитатор». Учитывая, что это довольно редкое заболевание, верный диагноз обычно ставится далеко не сразу.
В среднем инкубационный период болезни составляет 9 дней (от 1 до 21 дня), однако первые симптомы могут появиться даже менее чем через сутки, если заражение произошло при вдыхании инфекции.
При остром течении чаще всего развивается сепсис во всех своих проявлениях. По данным из статьи, опубликованной в 2019 году в журнале Australian journal of general practice, более половины острых пациентов имеют бактериемию, а у каждого пятого развивается септический шок. Чаще всего происходит поражение легких: у взрослых - более чем в половине случаев, у детей - в 20% случаев.
А вот поражение кожи чаще наблюдается у детей - в 60% случаев по сравнению с 13% случаев у взрослых. При этом кожный мелиоидоз обычно проявляется в виде одиночного поражения в месте проникновения инфекции, которое не поддается терапии антибиотиками.
Бывает также, что абсцессы обнаруживаются на внутренних органах - в селезенке, печени, надпочечниках и почках. Австралийские врачи сообщают, что у 18% мужчин отмечаются поражения предстательной железы.
В 4% случаев развивается очень опасное, но довольно редкое осложнение - энцефаломиелит. Известно о случаях остеомиелита и септического артрита, поражениях перикарда, абсцессах мошонки и других весьма необычных проявления мелиоидоза.
В 11% случаев, когда болезнь длится более 2 месяцев, развивается хронический мелиоидоз.
Австралийские и таиландские врачи указывают на факторы повышенного риска заболевания мелиоидозом:
- сахарный диабет,
- алкоголизм,
- хронические болезни почек и легких.
Конечно, чаще всего заражаются люди, деятельность которых так или иначе связана с водой и почвой. Неудивительно, что, как упоминали выше, мелиоидоз - сезонное заболевание, по времени привязанное ко времени дождей. Причем в сезон максимального риска из-за того, что инфекция чаще передается ингаляционным путем, инкубационный период короче, а болезнь чаще имеет симптомы пневмонии и чаще приводит к развитию септического шока и смерти.
Потенциальное оружие
Мы не зря упоминали сап в начале нашей статьи. Возбудитель сапа, близкий родственник бактерии, вызывающей мелиоидоз, изучался как потенциальное биологическое оружие. Целью его должны были быть лошади противника. B. pseudomallei тоже считается потенциальным бактериологическим оружием, и цель его - люди. А вакцины от мелиоидоза не существует. Возможно поэтому в последние годы интерес к буркхолдериям усилился.
А пока врачи перечисляют правила безопасности, соблюдение которых должно снизить риски заражения этой необычной инфекцией:
Читайте также: